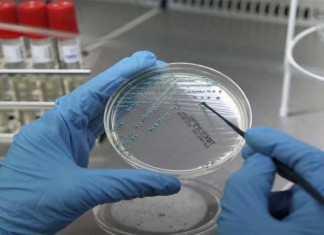

La salud sexual de los hombres: ¿los suplementos son seguros?
Las drogas legales de venta libre - fármacos/químicos - vendidos sin receta (Over-the-counter en ingles), así como los suplementos dietéticos y terapias para mejorar...
La pobreza vinculada a la depresión infantil y cambios en la...
Muchas consecuencias negativas están vinculadas al desarrollo humano bajo un estado de pobreza , y los investigadores de la Universidad de Washington de St....
Adolescentes que consumen cannabis en riesgo de esquizofrenia
La exposición a la marihuana en la adolescencia provoca cambios en el cerebro similares a la esquizofrenia, según un estudio publicado en la revista...
Una sesión de cachimba ofrece 125 veces el humo de un...
Los perjuicios para la salud del consumo de cigarrillos son, por ahora, muy bien conocidos por el público en general. Pero ¿qué hay de...
Análisis de orina para las etapas tempranas de Alzheimer a un...
Un nuevo estudio en ratones sugiere que puede ser posible detectar las primeras etapas de la enfermedad de Alzheimer a partir del olor de...
Nanosensores: ¿el futuro de la medicina de diagnóstico?
Un objetivo fundamental de la medicina de diagnóstico es ser capaz de diagnosticar problemas de salud lo antes posible, lo que permite a los...
¿E-cigarrillos podrían reducir la posibilidad real de dejar de fumar?
Aunque los cigarrillos electrónicos son ampliamente comercializados como una ayuda para dejar de fumar, un estudio publicado en The Lancet Medicina Respiratoria, sugiere que...
Neuronas motor y locomoción: aún más complejo de lo que pensábamos
Pionera investigación publicada en Nature esta semana muestra que el papel de las neuronas motoras en la locomoción es mucho más complejo de lo...
El estrógeno puede debilitar virus de la gripe en las mujeres
Un nuevo estudio podría explicar por qué la gripe parece impactar más a los hombres que a las mujeres. Los investigadores que probaron diversas...
¿Podría el exceso de ácido fólico reducir las defensas del sistema...
Muchos de nosotros estamos familiarizados con la importancia de la ingesta de ácido fólico para las mujeres embarazadas como forma de prevenir defectos del tubo...
El virus Zika se está extendiendo por las Américas
El número de recién nacidos con microcefalia subió fuertemente en Brasil y puede estar asociada con el virus Zika, quien llegó al país en...
¿Cómo los perros pueden reconocer las emociones humanas?
Llamando a todos los dueños de perros: ¿su amigo de cuatro patas parece saber cuando te sientes triste, feliz o enojado? Si es así,...